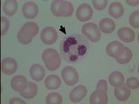
中性粒細胞

簡介
中性粒細胞
中性粒細胞絕大部分的粒細胞屬中性粒細胞。每微升血液中約有4500箇中性粒細胞。由於這些細胞的細胞核的形態特殊,又稱為多形核白細胞。中性粒細胞在血管內停留的時間平均只有6-8小時,它們很快穿過血管壁進入組織發揮作用,而且進入組織後不再返回血液中來。在血管中的中性粒細胞,約有一半隨血流循環,通常作白細胞計數隻反映了這部分中性粒細胞的情況;另一半則附著在小血管壁上。同時,在骨髓中尚貯備了約兩萬五千億個成熟中性粒細胞,在機體需要時可立即動員大量這部分粒細胞進入循環血流。
來源
 中性白細胞浸潤圖片
中性白細胞浸潤圖片中性粒細胞來源於骨髓的造血幹細胞,在骨髓中分化發育後,進入血液或組織。在骨髓、血液和結締組織的分布數量比是28:1:25,成年人血液中中性粒細胞的數量約占白細胞總數的55%一70%。中性粒細胞屬多形核白細胞的一種,由於其數量在粒細胞中最多,因此有人將多形核白細胞指中性粒細胞。
含量
中性粒細胞占白細胞的70%,是外周血循環和免疫系統中含量最豐富的白細胞。各類白細胞百分比為:
(1)嗜中性粒細胞50~70%,
(2)嗜酸性粒細胞0.5~5%,
(3)嗜鹼性粒細胞0~1%,
(4)淋巴細胞20~40%,
(5)單核細胞3~8%。
(“嗜中性粒細胞”即中性白細胞)
健康成人白細胞總數為4000~10,000/立方毫米。外周血塗片檢查中,中性粒細胞平均量為330飛升,直徑為12-15微米(µm)。與嗜酸性細胞和嗜鹼性細胞一起,合稱多核粒細胞。
正常中性粒細胞的範圍各實驗室有別,但中性粒細胞計數在2.5-7.5×109/升的屬正常範圍。非活化的中性粒細胞在外周血中的平均半衰期約為4-10小時。
結構特點
 中性粒細胞
中性粒細胞 為數量最多的白細胞。占白細胞50-70%,細胞直徑10-12µm。核呈深染的彎曲桿狀(馬蹄鐵形)或分葉狀,分葉核一般為2~5葉,葉間有纖細的縮窄部相連,正常人以2~3葉者居多。核的葉數與細胞在血流中停留的時間成正變。當機體受細菌嚴重感染時,大量新生細胞從骨髓進入血液,桿狀核與2葉核的細胞增多,稱為核左移;若4~5葉枝的細胞增多,稱為核右移,表明骨髓的造血功能發生障礙。中性粒細胞的胞質呈淺粉紅色,含有許多細小顆粒,其中淺紫色的為嗜天青顆粒(azurophilicgranule),淺紅色的為特殊顆粒(specificgranule)。嗜天青顆粒約占顆粒總數的20%,電鏡下顆粒較大,直徑0.6~0.7µm,呈圓形或橢圓形,電子密度較高。它是一種溶酶體,含有酸性磷酸酶、髓過氧化物酶和多種酸性水解酶類等,能消化吞噬的細菌和異物。特殊顆粒約占顆粒總數的80%,電鏡下顆粒較小,直徑0.3~0.4µm,呈啞鈴形或橢圓形[圖片04:中性粒細胞的超微結構]。特殊顆粒是一種分泌顆粒,內含溶菌酶、吞噬素(Phagocytin)等,吞噬素也稱防禦素(defensin),具有殺菌作用。
中性粒細胞具有活躍的變形運動和吞噬功能,起重要的防禦作用。其吞噬對象以細菌為主,也吞噬異物。中性粒細胞在吞噬、處理了大量細菌後,自身也死亡,成為膿細胞。中性粒細胞從骨髓進入血液,約停留6~8小時,然後離開,在結締組織中存活2~3天。
作用
中性粒細胞在血液的非特異性細胞免疫系統中起著十分重要的作用,它處於機體抵禦微生物病原體,特別是在化膿性細菌入侵的第一線,當炎症發生時,它們被趨化性物質吸引到炎症部位。由於它們是藉糖酵解獲得能量,因此在腫脹並血流不暢的缺氧情況下仍能夠生存,它們在這裡形成細胞毒存在破壞細菌和附近組織的細胞膜。由於中性粒細胞內含有大量溶酶體酶,因此能將吞噬入細胞內的細菌和組織碎片分解,這樣,入侵的細菌被包圍在一個局部,並消滅,防止病原微生物在體內擴散。當中性粒細胞本身解體時,釋出各溶酶體酶類能溶解周圍組織而形成膿腫。
 中性粒細胞增多的機制
中性粒細胞增多的機制中性粒細胞的細胞膜能釋放出一種不飽和脂肪酸——花生四烯酸,在酶的作用下,由它再進一步生成一組旁分泌激素物質,如血栓素和前列腺素等,這類物質對調節血管口徑和通透性有明顯的作用,還能引起炎症反應和疼痛,並影響血液凝固。
中性粒細胞內含許多彌散分布的細小的淺紅或淺紫色的特有顆粒,顆粒中含有髓過氧化物酶、酸性磷酸酶、吞噬素、溶菌酶等。髓過氧化物酶是中性粒細胞所特有,即使在有強吞噬作用的巨噬細胞中也極少或完全沒有這種酶。在細胞化學上,一般將這種髓過氧化物酶作為中性粒細胞的標誌。中性粒細胞具有很強的趨化作用。所謂趨化作用,就是細胞向著某一化學物質刺激的方向移動。對中性粒細胞起趨化作用的物質,稱為中性粒細胞趨化因子。中性粗細胞膜上有趨化因子受體,受體與趨化因子結合,激活胞膜上的鈣泵,細胞向前方伸出片足,使細胞移向產生趨化因子的部位。
中性粒細胞的片足與產生趨化因子的異物接觸後,接觸處周圍的胞質形成隆起即偽足,接觸部位的細胞膜下凹,將異物包圍,形成含有異物的吞噬體或吞噬泡。中性粒細胞膜表面有IgGFc受體和補體C3受體,可加速吞噬作用。被吞噬的異物裹有抗體和補體時,與中性粒細胞膜上的相應受體結合,而加強了細胞對它的吞噬作用,稱為調理作用。細胞隨著吞噬作用的開始,導致細胞膜紊亂而引起呼吸爆發,細胞耗氧量增加,產生大量的過氧化物及超氧化物等細胞毒性效應分子,對寄生蟲具有殺傷活性。在IFN-γ和TNF刺激下,則可產生更多的過氧代謝陰離子,殺死胞外寄生蟲。中性粒細胞在殺死吞噬的細菌等異物後,本身也死亡,死亡的中性粒細胞稱為膿細胞。
 中性粒細胞減少的機制
中性粒細胞減少的機制中性粒細胞受細菌產物、抗原抗體複合物等作用時,細胞的顆粒內容物向細胞外釋放。釋出的酸性蛋白酶和中性蛋白酶,可以分解血管基膜、腎小球基膜、結締組織的膠原蛋白與彈性蛋白以及血漿中的補體C5、C15和激肽原等。其分解產物有的又是中性粒細跑趨化因子,能吸引更多的中性粒細胞。中性粒細胞釋放的物質中,還有嗜酸性粒細胞趨化因子、中性粒細胞不動因子(NIF)、激肽酶原、血纖維蛋白溶酶原、凝血因子、白三烯等。
除了在抗感染中起重要的防禦作用外,中性粒細胞可引起感染部位的炎症反應並參與寄生蟲感染引發的變態反應,從而引起免疫病理損害。抗體直接作用於組織或細胞上的抗原,中性粗細胞通過其Fc受體與靶細胞表面的IgGFc段結合,發揮ADCC作用,從而導致細胞毒型變態反應損害;當抗原抗體比例適合而形成19S大小的免疫複合物,不易被吞噬,沉積於毛細血管壁,激活補體,吸引中性粒細胞至局部。中性粒細胞通過Fc受體和C3b受體與免疫複合物結合併吞噬之。吞噬過程中脫顆粒,釋放出一系列溶酶體酶類,造成血管和周圍組織的損傷;在IgE介導的速髮型變態反應的部位,也有中性粒細胞的聚集,說明中性粒細胞也參與了速髮型變態反應導致的病理損害。
生理學變異
⒈升高嬰兒約升高220%(皮質激素、腎上腺治療),用力、艱苦的鍛鍊約升高40%,婦女妊娠約升高23%,吸菸約升高18%,晝夜委律晚上約升高14%,黃體期約升高9%;
⒉降低4-14歲兒童約降低11%,月經期約降低15%,絕經約降低18%,黑色人種約低40%;
3.外周血中性粒細胞一天記憶體在著變化,下午比早晨高劇烈運動或勞動後,高溫、嚴寒、飽餐、淋浴後、妊娠後期、分娩時也增高。
病理學變異
 中性白細胞邊集和滲出
中性白細胞邊集和滲出⒈增加見於骨髓增殖綜合症、細菌感染、某些寄生蟲病、組織局部缺血或壞死、癌和何杰金氏病、急性出血和急性溶血之後、代謝性疾病(痛風危象、糖尿病酸中毒、腎功能不全)、炎症綜合性、變態反應和各種中毒。
⒉減少骨髓發育不全、骨髓入侵(成少突神經膠質細胞的造白細胞組織增生、部分成髓細胞性白血病)、病毒感染、傷寒、副作寒、某些寄生蟲病(瘧疾、黑熱病)、甲狀腺機能亢進、脾功能亢進、瓦爾登斯特倫病、多發性骨髓瘤、費爾提綜合徵、貧血(缺鐵、缺葉酸、維生素B12缺乏)、放射線(如:定位治療)、粒細胞缺乏症(中毒:匹拉咪痛、吩噻嗪、保泰松、抗甲狀腺藥等;免疫-免疫變態反應性疾病;全身性疾病)。
藥物影響
⒈增加考的松和氫化考的松能刺激骨髓造血機能,使中性粒細胞增加。煙酸可使中性粒細胞增加。煙醯胺用藥2g,4小時後中性粒細胞可增加40%,長期使用鋰可致中性粒細胞增加,停藥後即恢復。
⒉減少苯妥英鈉、三甲雙酮、奮乃靜、氯丙嗪、撲熱息痛、消炎痛、羥保泰松、安替比林、雙氫氯噻嗪(一時性)、地高辛、普魯卡因醯胺(一時性嚴重減少)、氯噻嗪、速尿、利尿酸、氯噻酮、華法令、甲亢平、甲碘丁脲(一時性)、維生素A、氨苄青黴素、二甲氧苯青黴素鈉、青黴素、羥苄青黴素(一時性)、先鋒黴素щ、先鋒黴素I(N減少、少見總數減少)、強力黴素、四環素(一時性)、氯黴素(毒性作用或至再障),灰黃黴素(可減少到20%伴總數降低)、利福平、異煙肼、氨基水楊酸、乙醇、瘤可寧(嚴重減少N)、環磷醯胺、硫唑嘌呤、硫秋水仙鹼(N減少,淋巴細胞增加)。
臨床意義
(1)中性粒細胞增多
1)急性感染或炎症:如化膿性球菌、某些桿菌(如大腸桿菌和綠膿桿菌等)、真菌、放線菌、病毒(如流行性出血熱、流行性乙型腦炎和狂犬病等)、立克次體如斑疹傷寒、螺鏇體(如鉤端螺鏇體和梅毒等)、寄生蟲(如肺吸蟲等)。
 中性粒細胞從血管遷移至細胞基質.
中性粒細胞從血管遷移至細胞基質.增高程度與病原體種類、感染部位、感染程度、機體反應性有關。如急性化膿性膽囊炎,WBC>20×109/L可作為診斷標準之一。如急性胰腺炎,WBC、中性粒細胞增高與炎症程度成正比,WBC>10×109/L時,水腫性急性胰腺炎占67.5%,壞死性急性胰腺炎達78.6%,中性粒細胞>85%時,水腫性急性胰腺炎占86.2%,壞死性急性胰腺炎占88.5%,死亡率高達100%.如腸缺血、壞死破裂,WBC>10×109/L可作為早期壞死指標之一。
如輕度感染,WBC可正常,但中性粒細胞百分率增高;中度感染,WBC可達(10~20)×109/L,中性粒細胞百分率增高,並伴有核左移;嚴重感染(如菌血症、敗血症、膿毒血症),WBC明顯增高可達(20~30)×109/L,中性粒細胞百分率明顯增高,並伴明顯核左移和中毒改變;上述情況說明機體反應良好。如感染過重,WBC不高,但核左移明顯,患者可能處於中毒性休克狀態,原因是白細胞再分布,聚集於內臟血管內;或白細胞大量逸出血管壁,趨向病患部位;或骨髓暫時供應不足。
2)廣泛組織損傷或壞死:如嚴重外傷、手術創傷、大面積燒傷、凍傷、血管栓塞(如心肌梗死和肺梗死等)。在12~36h內WBC增高,達l0×109/L以上,中性分葉核粒細胞增高。
3)急性溶血:紅細胞大量破壞、紅細胞分解產物刺激骨髓貯備池中粒細胞釋放。
4)急性失血:如急性大出血、消化道大量出血、內臟破裂(如脾破裂或輸卵管妊娠破裂等)。急性大出血,WBC在1~2h內迅速增高,達(10~20)×109/L,中性分葉核粒細胞增多。消化道大出血、內臟破裂,WBC增高,PLT也增高,與骨髓貯備池中細胞釋放有關,但此時RBC和Hb仍可正常,與體內血漿和血細胞比值尚未改變有關,所以,WBC增高可作為早期診斷內出血的指標之一。
5)急性中毒:外源性中毒(如化學物質、汞、鉛、安眠藥、昆蟲毒、蛇毒、毒蕈等)、內源性中毒(如尿毒症、糖尿病酮症酸中毒、子癇、內分泌疾病危象等)。以中性分葉核粒細胞增高為主。
6)惡性腫瘤:如非造血系統惡性腫瘤,WBC持續增高,以中性分葉核粒細胞增多為主,主要機制為:腫瘤組織壞死分解產物刺激骨髓粒細胞釋放;某些腫瘤細胞產生促粒細胞生成因子;腫瘤細胞骨髓轉移,破壞骨髓對粒細胞釋放的調控作用。
7)其他原因:如類風濕性關節炎、自身免疫性溶血性貧血、痛風、嚴重缺氧、套用皮質激素、腎上腺素、氯化鋰等
(2)中性粒細胞減少:
1)革蘭陰性桿菌感染,如傷寒、副傷寒;
2)某些病毒感染,如流感病毒;
3)慢性理化損傷、機體長期接觸鉛、汞、苯等;某些藥物如氯黴素、合黴素;長期接受放射線及放化療患者;
4)系統性紅斑狼瘡等自身免役性疾病;
5)再生障礙性貧血(再障)等血液病;
6)脾功能亢進、甲狀腺功能亢進(甲亢)。
7)某些寄生蟲病如瘧疾、黑熱病。
中性粒細胞構成“人體天網”
什麼是人體天網
德國科學家在觀察人體免疫系統對付細菌的過程中意外發現,在那些被人體滅菌勇士白血球殺死的細菌周圍,經常會看到一些絲狀體物質。起初,他們以為這是顯微鏡的鏡片不乾淨導致的觀察錯覺。但後來他們發現,這些絲狀物總是在細菌進入人體後,很快就出現在細菌周圍。它們相互纏繞,構成了網。這些網就像蜘蛛網那樣,能夠迅速把細菌橫七豎八地黏在上面,從而將細菌擒拿。隨後,這些網就密切配合人體白細胞里的其他物質,把被擒拿的細菌毒殺或者吞吃掉。
更為奇特的是,這種由絲狀體物質構成的網還能對人體內健康的細胞起到保護作用。實驗發現,在對付病毒的戰鬥中,有一種細胞分泌出來的蛋白酶在同細菌作戰的時候,有時候會傷及無辜,給人體健康細胞造成傷害。為了避免或減少這種傷害事件的發生,這個網憑藉自身的黏性,主動把這些蛋白酶集中到病菌密集的局部地方,幫助它們認準來犯之敵,同時避免誤傷健康細胞。
最讓人感動的是,這些由絲狀體物質編成的網,在發揮完殺敵和護體作用後,就自行化解,神秘地消失了。
什麼是物質編織
德國科學家通過細緻觀察和辨認,最後揭開了謎底。原來,白血球里的中性粒細胞在發現細菌入侵的敵情後,會馬上奔赴疆場,與細菌拼殺。這些投入到疆場的中性粒細胞注定要成為烈士,因為它們就像是過河的小卒,從不知道退路在哪裡,而且它們的壽命只有幾個小時。這些投入疆場的勇士,在與細菌拼殺到筋疲力盡的時候,便自行“剖腹”解體,從體內拋出絲狀體物質。眾多勇士的絲狀體物質纏繞在一起,就構成了細菌難逃的“天網”。讓人驚訝的是,構成“天網”的絲狀體物質,恰恰就是隱藏在中性粒細胞內部的DNA。
DNA竟然會在危急時刻挺身而出,織“網”殺敵——這可是長久以來有關DNA的從未有過的重大發現。
用“天網”破解謎案
人體內由DNA編織的“天網”被發現後,這種奇特現象立即觸發了許多醫學家的聯想和靈感。他們發現,過去許多非常難解的醫學謎案,現在看來可能與人體“天網”有關。
不孕症問題就是一例。有些夫婦婚後多年不能生育,根本原因是什麼?長久以來,醫學界一直是說法眾多,莫衷一是。前不久,美國研究人員發現,不孕症竟然與“天網”有神秘聯繫。研究人員在對母馬進行人工授精的過程中發現,中性粒細胞在母馬體內遇到人工輸入的公馬的精子時,也會拋出“天網”,將精子捕獲。中性粒細胞為什麼要阻擋精子呢?原來有的精子本身攜帶有細菌,這使得中性粒細胞誤以為它們都是細菌,所以只好六親不認,統統將其拿下。但精子也有自己的逃生絕活兒,它們本身攜帶有一種能夠將“天網”網絲熔化開的特殊物質,因此,那些健康的精子只消在“天網”上停留片刻,就會勝利大逃亡了。如果“天網”過密、過多,精子還能擺脫束縛去與卵子匯合孕育下一代嗎?研究人員推斷,這種精子被束縛在“天網”上的情況肯定會存在。由此,他們推測,人的不孕症問題很可能是由女性體內的中性粒細胞拋出的“天網”過密、過多導致的。
還有一種很難找到癥結的疾病,今天看來,也和人體“天網”有關。這種病叫作先天性黏液稠厚症,它的特點是人體肺部的分泌物過於黏稠,很容易堵塞人的呼吸通道,使人斷氣而亡。奇怪的是,那些分泌物中總是有數量極大的DNA。長久以來,醫學專家只知道這種疾病肯定和基因有關,但其中的疾病製造內幕總是弄不清楚。現在,他們才明白,這很可能是中性粒細胞在肺部拋出的“天網”過密、過多所導致的。

